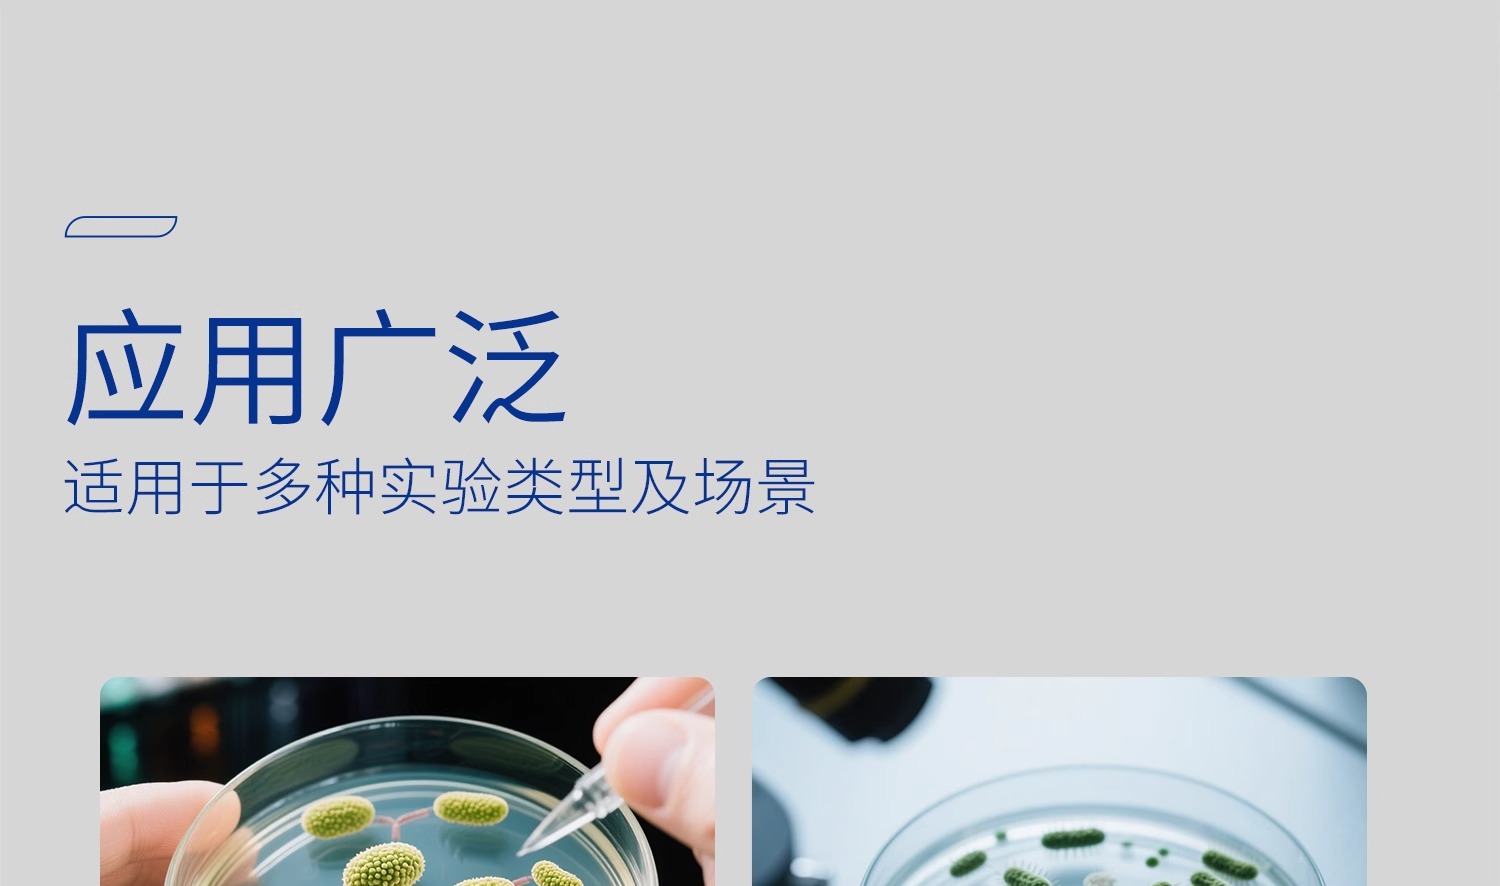

中文版
English
加入收藏
玻璃培养皿
产品名称:玻璃培养皿
产品品牌:湘玻
产品规格:
-
100mm 120403002
-
120mm 120403003
-
150mm 120403004
-
180mm 120403005
-
200mm 120403006
-
60mm 120403007
-
75mm 120403008
-
90mm 120403009